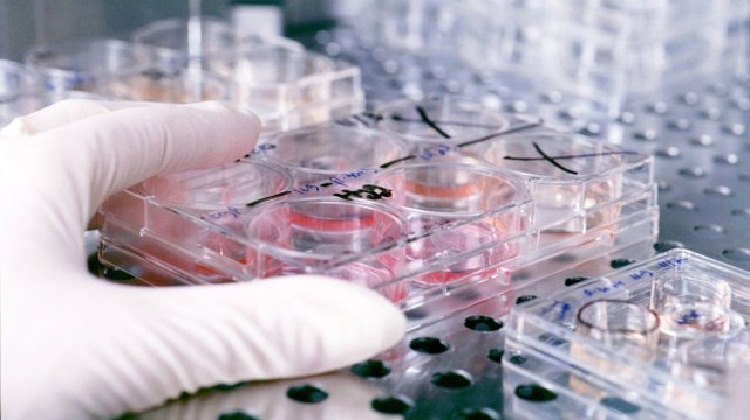
How Science (Lack Of It) Is Pulling India Behind When It Should Have Done The Opposite

Science and defence are the two most important factors in the development of a country. Any layman would agree to the fact that it is in fact these two sectors which need to be the most looked after by any government if it wants to uplift the country to a higher level. But in our country, these are two worst affected sectors with the new government coming to the centre. A year has passed with the BJP government at the helm of affairs in New Delhi, but the two most important sectors of the country are still hit hard by the inefficiencies of the government.
Coming to the defence sector first, the Ex Servicemen Association was a target of the electoral stunt by the Modi Government when he had promised them fulfilment of their long held demand for “Same Rank Same Pension”, following which a vast section of its members voted in favour of the BJP in 2014 but till date, no new developments have arrived on the scene. Forget the demand; even the pension has remained irregular with no incentive from the new government to rectify the errors of its predecessors. While the Ex servicemen feel betrayed, our PM is busy making tours abroad clinching new deals to satisfy God knows whom. The new recruits in 2014 from the post of lieutenant downwards have not yet been given a single penny of their salary. The army men are somehow managing their day to day budget by taking help from their seniors, who are at the very least getting paid. Not only this, no new purchases have been made in the defence sector too.
The problems in science are even more intimidating. It is surprising to many how Modi has been detaching science from development. While he speaks at length about the development of the country, he maintains a strict mum on the issue of science and scientific temper. The killing of ND still remains without a trial. The Sangh family has been rewriting the books in accordance with how they want science to be claiming plastic surgery and aeroplanes to be present in the Vedic age. Detailed seminars are held on the Vedic age and the usefulness of cow urine, without any viable proof, while beef, a heavy protein food for the lower income groups of the country is banned without a prerogative.
The condition of the various prestigious research institutions of the country is even more downtrodden. The budgets of many such institutions have remained stagnant over a long time. The stipend for researchers has become from stagnant to irregular. There was a joint protest against the irregular and less stipend by the research scholars recently, so you can very well imagine the economic disparity faced by them, the levels of which have forced even the most studious of brains in the country to take the path of the road to protest against the policies of the government.
With the government’s stress on make in India and e-platforms and all, there was the hope of a right and golden future in many of the science students of the country, but as time passed by, the golden slowly turned grey. The hopes were vandalised when institutions like the CSIR and IARI remain without their heads for over a year now, ad-hoc committees have been running the show there. A joint head was selected for the CSIR and the Petroleum institute at Dehradun under the CSIR, but as we all know, these are highly acclaimed institutions and not neighbourhood schools which can be maintained by a joint head.
Such issues of mismanagement and negligence have not only slowed the progress of the research and development projects but have dealt a striking blow to the researchers and aspiring scientist, who have at times been advised blatantly to seek private funding, as the government has become too ‘inefficient and uninterested’ to fund their research. It’s only natural for a party which stems from the Sangh Parivar, a Hindutwa unit, to demoralise the study of science, but BJP needs to understand that gone are the days when religion was the clarion call for the masses. In today’s world, it is science that provides the path for development, and development alone should be the aim of the government and by development, we mean the development of the country as a whole, not only the business class for which the Prime Minister has been found to have a soft spot.
Note: Rise For India is a citizen driven opinion based media website and the views expressed in the posts are solely that of the authors. If you disagree with the opinion expressed by the writer, please feel free to use our commenting system to start a constructive discussion about the same.